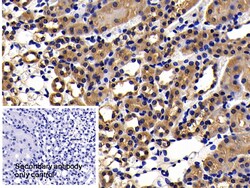
Invitrogen APAF1 Polyclonal Antibody, Invitrogen 20 &mu;L; Unconjugated:Antibodies,

missing translation for 'onlineSavingsMsg'
Learn More
Learn More
Invitrogen™ APAF1 Polyclonal Antibody, Invitrogen™
Rabbit Polyclonal Antibody
Brand: Invitrogen™ PA5145498
This item is not returnable.
View return policy
Description
APAF1 gene encodes a cytoplasmic protein that initiates apoptosis. This protein contains several copies of the WD-40 domain, a caspase recruitment domain (CARD), and an ATPase domain (NB-ARC). Upon binding cytochrome c and dATP, this protein forms an oligomeric apoptosome. The apoptosome binds and cleaves caspase 9 preproprotein, releasing its mature, activated form. Activated caspase 9 stimulates the subsequent caspase cascade that commits the cell to apoptosis. Alternative splicing results in several transcript variants encoding different isoforms.
Specifications
| APAF1 | |
| Polyclonal | |
| Unconjugated | |
| APAF1 | |
| 6230400I06Rik; APAF1; APAF-1; Apaf1l; apoptotic peptidase activating factor 1; apoptotic protease activating factor 1; apoptotic protease-activating factor 1; CED4; DKFZp781B1145; fog; forebrain overgrowth; KIAA0413; mKIAA0413 | |
| Rabbit | |
| Antigen affinity chromatography, Protein A | |
| RUO | |
| 11783, 78963 | |
| Store at 4°C short term. For long term storage, store at -20°C, avoiding freeze/thaw cycles. | |
| Liquid |
| Immunohistochemistry (Paraffin), Western Blot, Immunocytochemistry | |
| 0.5 mg/mL | |
| PBS with 50% glycerol and 0.05% Proclin 300; pH 7.4 | |
| O88879, Q9EPV5 | |
| APAF1 | |
| Recombinant Mouse APAF1 protein, Arg872-Phe1135 (Accession #O88879). | |
| 20 μL | |
| Primary | |
| Mouse, Rat | |
| Antibody | |
| IgG |
Product Content Correction
Your input is important to us. Please complete this form to provide feedback related to the content on this product.
Product Title
Spot an opportunity for improvement?Share a Content Correction